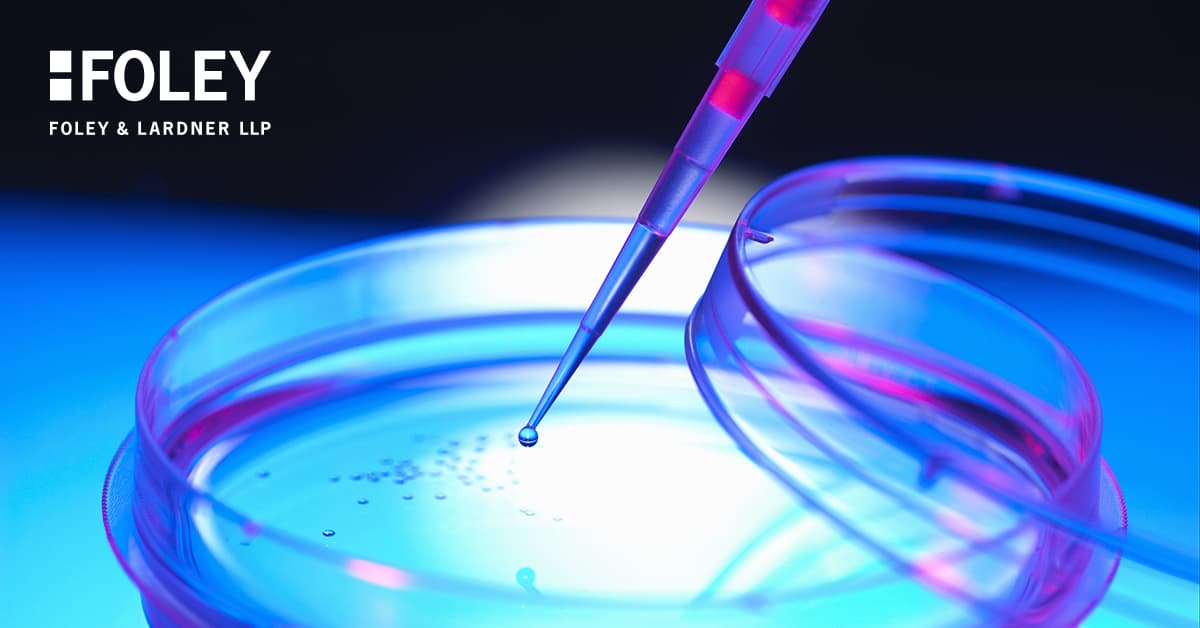
Markazlashtirilmagan klinik sinovlarni o’tkazishda mulohazalar

Klinik sinovlarda telesalomatlikdan foydalanish yangi bo'lmasa-da, COVID-19 tomonidan olib borilgan ijtimoiy uzoqlashish harakatlari muammoni hal qilmaguncha, bu usul ommalashtirilmagan.
Telesalomatlik orqali klinik sinov xizmatlarini taqdim etishdan manfaatdor bo'lgan kompaniyalar klinik sinovning klinik jihatlarini o'tkazish tibbiyot amaliyotining bir qismi ekanligi bilan shug'ullanishlari kerak. Ba'zilarning ta'kidlashicha, sinovning klinik jihatlari tibbiyot amaliyoti bilan bir xil emas. Boshqalar esa, noxush hodisa yuz berganda klinik yordam zarurligini ta'kidlaydilar
Davlat qonunchiligida klinik tadqiqotlarni bajarish tibbiyot amaliyotini tashkil etishi haqida dalillar mavjud. Tex. Admin ostida. Kodeks § 177.1 (2) (ta'kidlangan), Texas tibbiyot amaliyotida faol ishtirok etadiganlarni quyidagicha belgilaydi:
"Shifokor to'liq ish kunida har qanday ruhiy yoki jismoniy kasallik yoki buzilish yoki jismoniy nuqson yoki shikastlanishni tashxislash, davolash yoki davolashni taklif qilish bilan shug'ullanadi yoki kompensatsiya uchun alohida bemorlarga nisbatan bunday harakatlarni amalga oshiradi va klinik tibbiy tadqiqotlarni o'z ichiga oladi, klinik tadqiqot tibbiyoti amaliyoti, Amerika Tibbiyot Assotsiatsiyasining Tibbiy ta'lim bo'yicha aloqa qo'mitasi, Amerika Osteopatik Assotsiatsiyasi yoki Oliy tibbiy ta'lim bo'yicha akkreditatsiya kengashi tomonidan tasdiqlangan o'quv muassasasi yoki dasturda tibbiyot talabalari yoki rezidentlarini nazorat qilish va o'qitish va tibbiyot amaliyoti yoki sog'liqni saqlash xizmatlarini ko'rsatish bilan bog'liq professional boshqaruv, ma'muriy yoki nazorat faoliyati. Ushbu bo'lim maqsadlari uchun "to'liq ish vaqti" atamasi ma'lum bir yil davomida 40 hafta davomida haftasiga kamida 20 soatni bildiradi."
Texas, shuning uchun aniq o'z ichiga oladi "klinik tibbiy tadqiqotlar"tibbiyot amaliyotining ta'rifida, shuningdek, "tibbiyot amaliyoti yoki sog'liqni saqlash xizmatlarini ko'rsatish bilan bog'liq professional boshqaruv, ma'muriy yoki nazorat faoliyati". Garchi bir qator davlatlar bu masala bo'yicha jim bo'lishsa-da, sukut saqlash tadqiqot xizmatlari davlat amaliyot standartlariga muvofiq klinik yordam ko'rsatilmasligini anglatmaydi. Klinik tadqiqotlar o'z-o'zidan klinik yordam emas, degan argument mavjud, chunki klinisyenlar odatda Institutsional Tekshirish Kengashi (IRB) tomonidan tasdiqlangan protokolga amal qiladilar va har qanday muntazam yordam, hatto favqulodda vaziyatda ham, mahalliy litsenziyaga ega klinisyen tomonidan taqdim etiladi. . Shunga qaramay, Texas kabi shtatlarning mavjudligi, bu ta'rifda klinik tibbiy tadqiqotlarni aniq o'z ichiga oladi. tibbiyot amaliyoti bilan shug'ullanish klinik tadqiqotlarni qo'llab-quvvatlash xizmatlari maydoniga kiruvchi sub'ektlar amaldagi amaliyot standartlarini aniqlash haqida o'ylashda ushbu masalani ko'rib chiqishlari kerakligini anglatadi.
Garchi bir qator davlatlar bu masala bo'yicha jim bo'lishsa-da, sukut saqlash tadqiqot xizmatlari davlat amaliyot standartlariga muvofiq klinik yordam ko'rsatilmasligini anglatmaydi. Klinik tadqiqotlar o'z-o'zidan klinik yordam emas, degan argument mavjud, chunki klinisyenlar odatda Institutsional Tekshirish Kengashi (IRB) tomonidan tasdiqlangan protokolga amal qiladilar va har qanday muntazam yordam, hatto favqulodda vaziyatda ham, mahalliy litsenziyaga ega klinisyen tomonidan taqdim etiladi. . Shunga qaramay, Texas kabi shtatlarning mavjudligi, bu ta'rifda klinik tibbiy tadqiqotlarni aniq o'z ichiga oladi. tibbiyot amaliyoti bilan shug'ullanish klinik tadqiqotlarni qo'llab-quvvatlash xizmatlari maydoniga kiruvchi sub'ektlar amaldagi amaliyot standartlarini aniqlash haqida o'ylashda ushbu masalani ko'rib chiqishlari kerakligini anglatadi.
Klinik tadqiqotlar litsenziyalangan kasbning amaliyoti deb hisoblansa (masalan, Texasdagi tibbiyot), tibbiyot amaliyotiga qo'llaniladigan tegishli qonuniy talablar qo'llaniladi. Misol uchun, odatda, tibbiy xizmat ko'rsatuvchi provayderlar, agar tegishli istisnolar qo'llanilmasa, o'rganilayotgan sub'ekt joylashgan shtatda litsenziyaga ega bo'lishi kerak. Bundan tashqari, o'rganish sub'ektlari bilan o'zaro aloqada bo'lgan holda, amaldagi telesog'liqni saqlash standartlarini hisobga olish va ularga rioya qilish kerak.
Shifokor-bemor munosabatlarini mos ravishda yaratish, shifokor-bemor munosabatlarini yaratish va undan keyin qo'llab-quvvatlashda modallik talablari, masofadan turib retseptlash talablari, (agar mavjud bo'lsa) nazorat qilinadigan moddalarni retseptlash talablari, (agar mavjud bo'lsa) tele-sog'liqni saqlash amaliyoti uchun tibbiy rekord talablari, tele-sog'liqni saqlash. shaxsni tekshirish va oshkor qilish talablari va har qanday favqulodda yoki keyingi parvarish rejasi talablari.
Bitta talab markazlashtirilmagan klinik sinovlar kontekstida alohida e'tiborga olinadi. Klinik tadkikot bilan birga IRB tomonidan tasdiqlangan standart ma'lumotli rozilik bilan bir qatorda, bir qator shtatlarda bunday platformadan foydalanishning davolash usullari, xavflari va cheklovlari bilan bog'liq telesalomatlikdan foydalanishda maxsus rozilik talablari mavjud. Homiylar va saytlar klinik sinovda ishtirok etuvchi sub'ektlar uchun zarur bo'lgan roziliklarga qo'shimcha ravishda tele-sog'liqni saqlash tizimidan xabardor qilingan rozilikdan foydalanish kerakmi yoki yo'qligini ko'rib chiqmoqchi.
Har bir amaliyot standarti talabi va unga muvofiqligi har bir shtat tahlilini talab qiladi, bunda klinik tadqiqotlar tibbiyot amaliyoti deb hisoblanadi yoki, ehtimol, tibbiyot amaliyoti hisoblanadi. Bunday standartlarga rioya qilmaslik o'rganish joylari, tergovchilar va xodimlarni istalmagan majburlovlarga duchor qilishi mumkin. Tadqiqot homiylari tegishli klinik sinov shartnomasidagi vakolatlar va kafolatlar va telesalomatlikdan foydalanish protokol ishlab chiqishga qanday ta'sir qilishi yoki ta'sir qilmasligi haqida yaxshilab o'ylab ko'rishni xohlaydi.

![Sog’liqni saqlashda ma’naviyat kuchini ochish [PODCAST]](/_next/image/?url=https%3A%2F%2Fbackend.kasallik.uz%2Fwp-content%2Fuploads%2F2023%2F05%2FUnveiling-the-power-of-spirituality-in-health-care.jpg&w=3840&q=75)
Javoblar (0 )